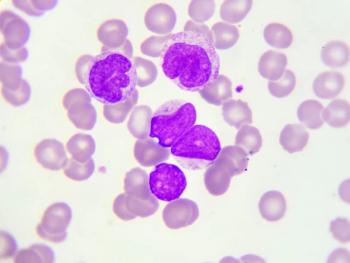

In patients with non-germinal center B cell–like diffuse large B-cell lymphoma, the combination of orelabrutinib plus R-CHOP revealed an overall response rate of 86.4%.
Your AI-Trained Oncology Knowledge Connection!
In patients with non-germinal center B cell–like diffuse large B-cell lymphoma, the combination of orelabrutinib plus R-CHOP revealed an overall response rate of 86.4%.
Findings from Cohort K of the EV-103 trial demonstrated a 64.5% overall response rate with enfortumab vedotin plus pembrolizumab in metastatic urothelial cancer.
Findings from the phase 2 BIONIKK trial demonstrated an association between treatment efficacy and increased in situ and immune expression.
Based on evidence from the phase 3 ADVANCE and RECOVER trials, the FDA has approved eflapegrastim-xnst injection to decrease the incidence of infection related to febrile neutropenia for patients with non-myeloid malignancies who are receiving treatment with myelosuppressive anti-cancer agents known to be associated with clinically significant neutropenia.
First results from the RADICALS-HD trial demonstrated improved metastasis-free survival with 2 years of androgen-deprivation therapy (ADT) plus radiotherapy in men with prostate cancer.
Patients with high-risk resectable melanoma experienced the highest event-free survival benefit when pembrolizumab was administered in the neoadjuvant settings vs the adjuvant setting
Trastuzumab deruxtecan demonstrates clinically meaningful benefit in patients with non¬–small cell lung cancer harboring HER2 mutations, according to results from the DESTINY-Lung02 trial.
Results from the phase 3 IPSOS trial showed a nearly doubled rate of 2-year overall survival with atezolizumab in patients with advanced non–small cell lung cancer.
Findings from the phase 1/2 ReFocus study highlighted that RLY-4008 is a potentially transformative agent for the treatment of FGFR inhibitor–naïve, FGFR-mutant cholangiocarcinoma.
The risk for disease progression or death was reduced by 27% with the addition of cabozantinib to nivolumab plus ipilimumab in patients with previously untreated renal cell carcinoma.
Result from the phase 3 KEYLINK-010 trial showed no statistically significant improvement in radiographic progression-free survival and overall survival when pembrolizumab and olaparib were used to treat molecularly unselected, previously treated metastatic castration-resistant prostate cancer vs novel hormonal agents.
Findings from the phase 3 CodeBreaK 200 trial show improved progression-free survival with sotorasib vs docetaxel in previously treated KRAS G12C-mutant non–small cell lung cancer.
Results from the phase 3 CANOPY-A trial failed to show improved disease-free survival with adjuvant canakinumab in completely resected non–small cell lung cancer.
Tucatinib as monotherapy and in combination with trastuzumab supported further investigation of the regimens in patients with metastatic HER2-positive colorectal cancer.
The final readout of the phase 2 TITAN-RCC trial highlighted an improvement in responses following an individualized regimen of nivolumab and ipilimumab boost after single-agent nivolumab in patients with advanced renal cell carcinoma.
Neoadjuvant treatment with cemiplimab led to near or complete disappearance of cutaneous squamous cell carcinoma in almost 64% of patients set to undergo surgery.
Kami J. Maddocks, MD, reviews findings from the SHINE trial comparing ibrutinib plus bendamustine/rituximab vs bendamustine/rituximab alone in newly diagnosed mantle cell lymphoma.
Findings from the phase 3 ADURA trial indicated that patients with EGFR-mutated, stage II to IIIA non–small cell lung cancer (NSCLC) experienced a promising reduction in risk of disease recurrence or death following treatment with adjuvant osimertinib.
Findings from the DESTINY-Breast04 trial indicated that patients with hormone receptor–positive, HER2-low metastatic breast cancer experienced promising quality of life following treatment with fam-trastuzumab deruxtecan-nxki.
Patients with with metastatic castration-resistant prostate cancer continued to derive notable benefit from treatment with first-line olaparib plus abiraterone acetate and prednisone or prednisolone compared with abiraterone monotherapy.
Long-lasting duration of response and prolonged survival were observed following treatment with MEDI15752 vs pembrolizumab among patients with treatment-naïve nonsquamous non–small cell lung cancer, according to findings from a phase 1b/2 trial.
Patients with advanced clear cell renal cell carcinoma given lenvatinib plus pembrolizumab had sustained overall survival and progression-free survival benefit vs sunitinib, according to updated results of the CLEAR trial.
Results from a presentation at 2022 ESMO showed DCC-3116 was tolerated in patients with RAS or RAF-mutant solid tumors.
At ESMO 2022, peripheral blood samples taken from patients with advanced or metastatic urothelial carcinoma treated on the phase 3 JAVELIN Bladder 100 trial showed there may be a potential to predict disease response to avelumab.
Findings from an updated safety and efficacy analysis of the phase 3 KEYNOTE-775 trial were consistent with the primary analysis and highlighted notable improvements in outcomes among patients with advanced endometrial cancer treated with lenvatinib and pembrolizumab vs physician’s choice.
Patients with newly diagnosed ovarian cancer with or without a high risk of progression experienced a progression-free survival benefit from treatment with maintenance rucaparib compared with placebo regardless of molecular characteristics.
Overall survival remained durable in patients with metastatic non–small cell lung cancer when tremelimumab was added to durvalumab plus chemotherapy in the frontline setting.
Despite the combination of enzalutamide plus abiraterone acetate and prednisolone (AAP) falling short in patients with metastatic hormone-sensitive prostate cancer, although androgen deprivation therapy plus AAP resulted in a clinically meaningful overall survival benefit.
Patients with localized recall cell carcinoma did not have improved disease-free survival with adjuvant nivolumab plus ipilimumab vs placebo.
Pembrolizumab plus chemoradiation did not meet statistically significant improvement in event-free survival for patients with locally advanced head and neck squamous cell carcinoma.